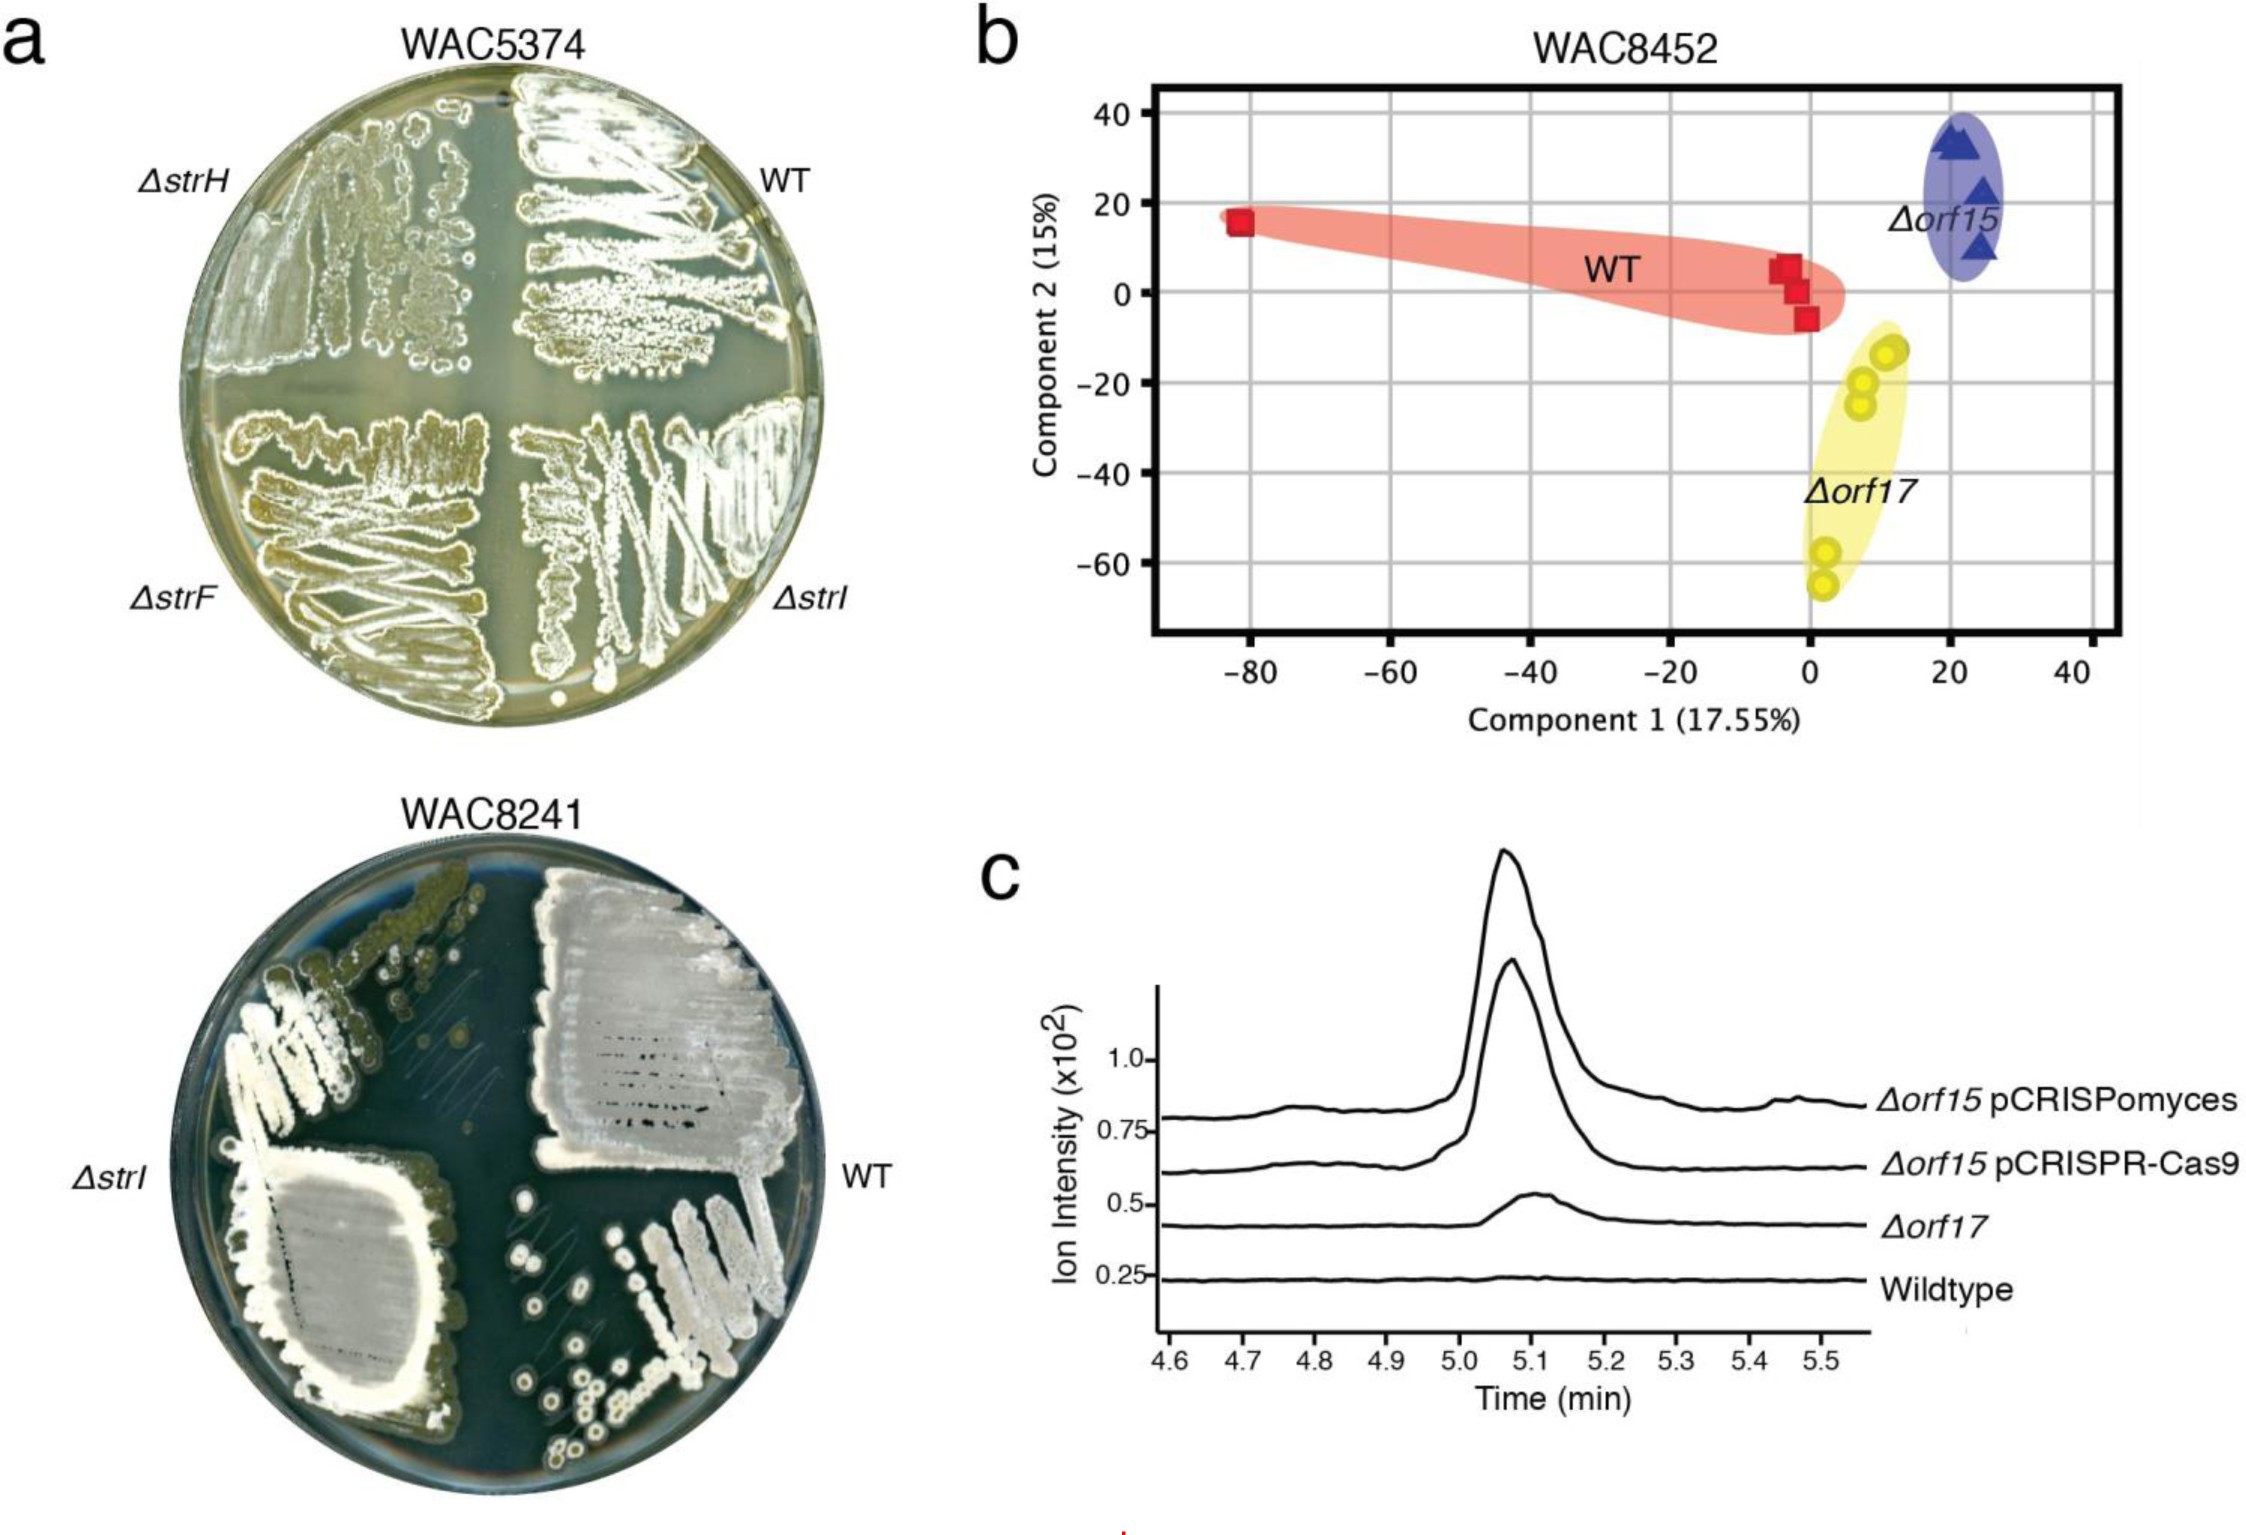
Supplementary Figure 5

Supplementary Figure 5: CRISPR-inactivated strains have an altered metabolic profile.
Global changes in metabolic flux of wild-type and knockout streptomycin or streptothricin producers were assessed globally by phenotypic analysis on solid media (A) and principle component analysis on high-resolution LC/MS profiles of n-butanolic extracts (B). Strains were analyzed as described in Fig. 2 of the main text. The streptomycin producers WAC5374 and WAC8241, and the streptothricin producer WAC8452 are shown here, while remaining strains are shown in Fig. 2. Replicates represent three independent fermentation analyzed in technical duplicate (n = 6). (C) High-resolution LC/MS analysis on the streptothricin producer WAC6273 reveal different metabolite profiles in CRISPR-inactivated strains compared to the wild-type strain. Extracted ion chromatograms for an unknown metabolite with m/z 650.333 are shown. Two independent fermentations and analysis gave similar results.
